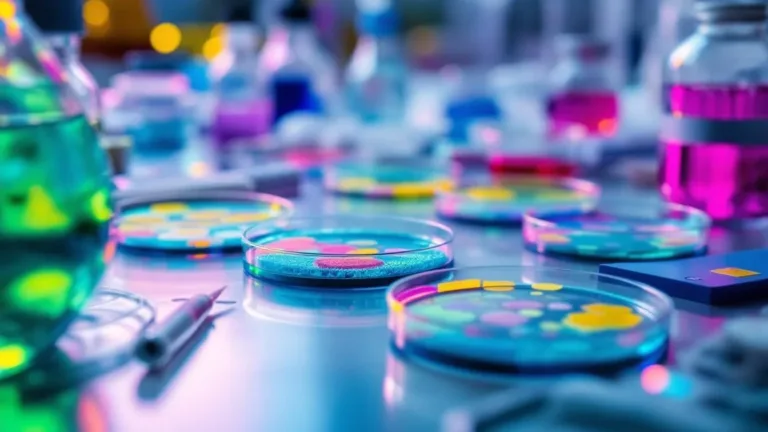
מה-זה-השתלת-מיקרוביום-ולמה-רופאים-משתמשים-בה-discover16x9.webp

איך להיפטר משומן במטבח בקלות וללא מאמץ עם טריק פשוט
ניקוי השומן במטבח עשוי להיראות כמו אתגר מתמשך, אבל ישנם פתרונות פשוטים שיכולים להקל על התהליך. עם חשיבה יצירתית ושימוש בחומרים זמינים בבית, אפשר להשיג תוצאות מרשימות בקלות ובמהירות. בשיטה פשוטה, ניתן להיפטר מהשומן שהצטבר על הקירות, התקרה והכלים, ולהחזיר את המטבח למצב נקי ומסודר. פתרונות אלו יעזרו לא רק לחסוך זמן, אלא גם להפוך …